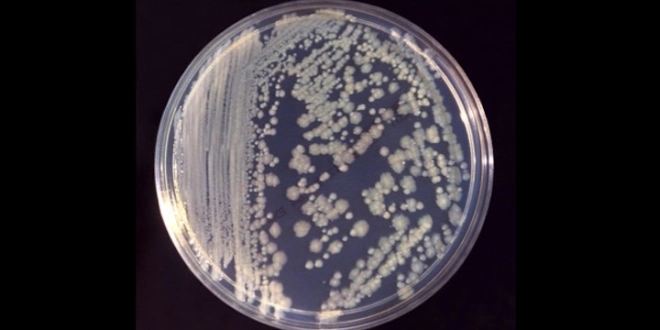

Tunisie : une bactérie à l’origine de la mort de 14 bébés dans une maternité
Une enquête révèle qu’une contamination bactérienne des poches de nutrition est à l’origine des 14 décès de bébés prématurés en mars dernier dans une maternité de Tunis.
Par La rédaction d'Allo Docteurs
Mis à jour le
Que s’est-il passé dans la maternité publique de Rabta, à Tunis ? Entre le 6 et le 15 mars 2019, 14 nourrissons prématurés sont décédés dans cet établissement. Un drame qui avait choqué le pays, entraîné la démission du ministre de la Santé Abderraouf Chérif et la destitution de plusieurs hauts responsables au sein du ministère. Le 25 avril, la publication d’un rapport fait la lumière sur les circonstances de cette affaire : il révèle qu’une infection bactérienne au sein de la maternité est à l’origine des décès.
A lire aussi : Démission du ministre de la Santé tunisien après le décès de 11 bébés
Des bactéries Enterobacter cloacae dans les poches de nutrition
Plus précisément, l’infection bactérienne mise en cause dans la mort des 14 bébés prématurés s’est produite lors de la période de préparation des poches de nutrition entre le 4 et le 8 mars, selon le président de la commission d'enquête, Mohamed Douagi : "L'enquête a démontré plusieurs défaillances concernant la salle de préparation des poches". Ainsi, "les poches utilisées ou celles qu’on s’apprêtait à utiliser, contiennent la bactérie Enterobacter cloacae […] qui se transmet par la main", a expliqué le président de la commission.
La bactérie Enterobacter cloacae est naturellement présente dans le tube digestif humain et animal mais devient pathogène lorsqu’elle contamine une muqueuse, une plaie ou qu’elle entre dans le tube digestif par voie orale. Elle est fréquemment impliquée dans des cas d’infection nosocomiale, comme ici à la maternité de Rabta.
Effectif humain, formation et contrôle de qualité insuffisants
Par ailleurs, de multiples défaillances ont également été révélées dont "l'absence d'effectif humain" suffisant, une "absence du contrôle de la qualité efficace et de la formation et de l'encadrement du personnel" au sein de ce service ainsi que le "non respect des bases de la stérilisation".
Après l'indépendance en 1956, le développement de la santé publique a été une priorité pour la Tunisie qui dispose à ce jour de 166 hôpitaux et 2.100 centres de santé, selon des chiffres officiels. Mais cet ancien fleuron du pays a été mis à mal par des problèmes de gestion et de financement, alors que la santé privée a prospéré.










